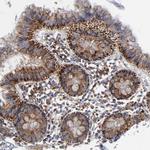
TrxR2 Antibody in Immunohistochemistry (Paraffin) (IHC (P))

Search
Invitrogen
TrxR2 Polyclonal Antibody
{{$productOrderCtrl.translations['antibody.pdp.commerceCard.promotion.promotions']}}
{{$productOrderCtrl.translations['antibody.pdp.commerceCard.promotion.viewpromo']}}
{{$productOrderCtrl.translations['antibody.pdp.commerceCard.promotion.promocode']}}: {{promo.promoCode}} {{promo.promoTitle}} {{promo.promoDescription}}. {{$productOrderCtrl.translations['antibody.pdp.commerceCard.promotion.learnmore']}}
产品信息
PA5-82080
种属反应
宿主/亚型
分类
类型
抗原
偶联物
形式
浓度
规格
纯化类型
保存液
内含物
保存条件
运输条件
RRID
产品详细信息
Immunogen sequence: CAGFLTGIGL DTTIMMRSIP LRGFDQQMSS MVIEHMASHG TRFLRGCAPS RVRRLPDGQL QVTWEDSTTG KEDTGTFDTV LWAIGRVPDT RSLNLEKAGV DTSPDTQKIL VDSREATSVP HIYAIGDVVE GRPELTPTAI MAGRLLVQRL F
Highest antigen sequence indentity to the following orthologs: Mouse - 80%, Rat - 80%.
靶标信息
The mammalian thioredoxin reductases (TrxRs) are a family of selenocysteine-containing pyridine nucleotide-disulfide oxidoreductases. All the mammalian TrxRs are homologous to glutathione reductase with respect to primary structure including the conserved redox catalytic site (-Cys-Val-Asn-Val-Gly-Cys-) but distinctively with a C-terminal extension containing a catalytically active penultimate selenocysteine (SeCys) residue in the conserved sequence (-Gly-Cys-SeCys-Gly). TrxR is homodimeric protein in which each monomer includes an FAD prosthetic group, a NADPH binding site and a redox catalytic site. Electrons are transferred from NADPH via FAD and the active-site disulfide to C-terminal SeCys-containing redox center, which then reduces the substrate like thioredoxin. The members of TrxR family are 55-58 kilodalton in molecular size and composed of three isoforms including cytosolic TrxR1, mitochondrial TrxR2, and TrxR3, known as Trx and GSSG reductase (TGR). TrxR plays a key role in protection of cells against oxidative stress and redox-regulatory mechanism of transcription factors and various biological phenomena.
仅用于科研。不用于诊断过程。未经明确授权不得转售。
篇参考文献 (0)
生物信息学
蛋白别名: Selenoprotein Z; SelZ; Thioredoxin reductase 2, mitochondrial; thioredoxin reductase 3; thioredoxin reductase beta; Thioredoxin reductase TR3; TR-beta; unnamed protein product
基因别名: GCCD5; KIAA1652; SELZ; TR; TR-BETA; TR3; TRXR2; TXNR2; TXNRD2
UniProt ID: (Human) Q9NNW7
Entrez Gene ID: (Human) 10587